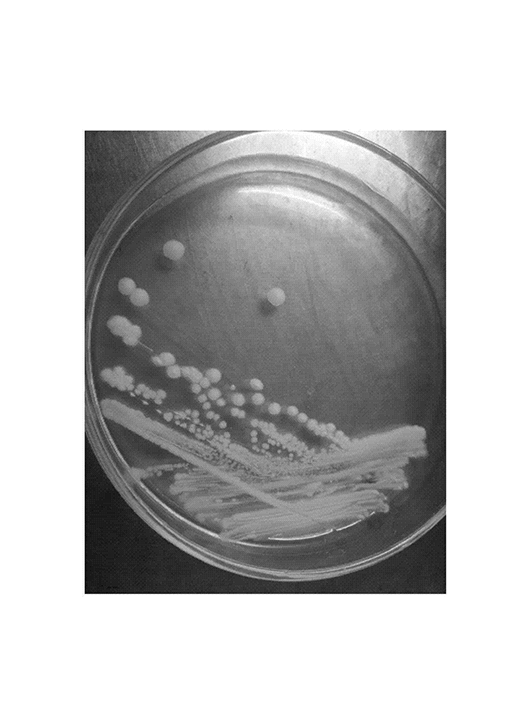
東方伊薩酵母
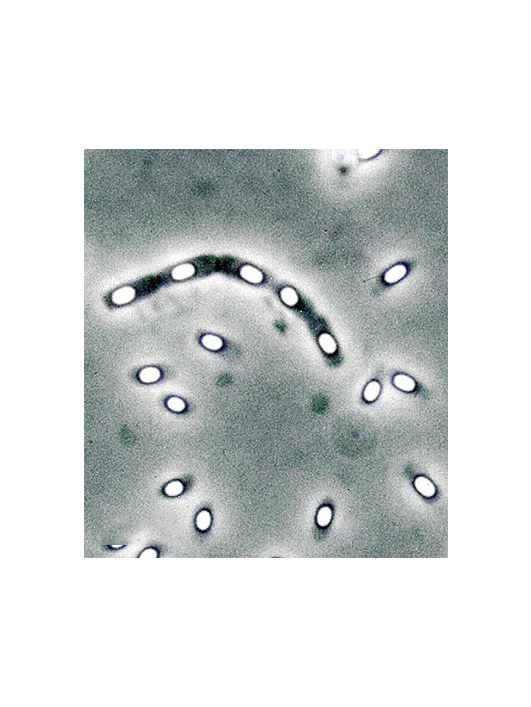
乳酸可魯維酵母

東方伊薩酵母
東方伊薩酵母(Issatchenkia orientalis)���,以形成子囊和子囊孢子的方式進(jìn)行有性繁殖的。兩個臨近的酵母細(xì)胞各自伸出一根管狀的原生質(zhì)突起�����,隨即相互接觸�、融合��,并形成一個通道���,兩個細(xì)胞核在此通道內(nèi)結(jié)合�����,形成雙倍體細(xì)胞核�����,然后進(jìn)行減數(shù)分裂����,形成4個或8個細(xì)胞核�。每一子核與其周圍的原生質(zhì)形成孢子�����,即為子囊孢子�,形成子囊孢子的細(xì)胞稱為子囊�。
有性繁殖
改善土壤質(zhì)量